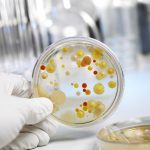
Причины и лечение молочницы после родов Молочница после родов

Кольпит – воспаление во влагалище. Возникает вследствие активации условно-патогенной флоры на фоне снижения защитных сил организма или же носит специфический характер, если вызывается определенными микроорганизмами, например, трихомонадами и т.п. Кольпит после родов – не всегда проявление половой инфекции. Что провоцирует воспаление во влагалище, какие симптомы патологии и насколько она опасна?
Причины появления кольпита после родов
В норме во влагалище у женщины, в том числе после родов, кислая среда, которая обусловлена жизнедеятельностью палочек Дедерлейна. При снижении их количества рН сдвигается в щелочную сторону (чаще всего), что создает оптимальные условия для размножения условно-патогенных и болезнетворных микроорганизмов. В итоге возникает кольпит.
Обычно при этом женщину начинают беспокоить различные выделения, часто обильные, странного (например, зеленого) цвета и с неприятным запахом.
Рекомендуем прочитать статью о молочнице после родов. Из нее вы узнаете о причинах и симптомах заболевания, особенностях лечения при грудном вскармливании.
А здесь подробнее об использовании тампонов после родов.
Кольпит после родов может вызывать беспокойство у многих женщин, и врачи выделяют несколько причин этого состояния. Во-первых, изменения гормонального фона, происходящие в послеродовом периоде, могут привести к нарушению микрофлоры влагалища, что способствует развитию воспалительных процессов. Во-вторых, травмы, полученные во время родов, могут стать предрасполагающим фактором для инфекции. Врачи рекомендуют обратить внимание на гигиену, избегать использования агрессивных моющих средств и носить свободное, дышащее белье. Для лечения кольпита могут быть назначены противовоспалительные препараты и пробиотики, восстанавливающие нормальную микрофлору. Важно также следить за состоянием иммунной системы и при необходимости консультироваться с гинекологом для выбора оптимального метода лечения.

Неспецифическое воспаление
В норме во влагалище могут существовать, но не в больших количествах, бактерии, которые способны вызывать воспаление и приводить к различным недугам.
Их называют условно-патогенными, так как болезнетворными они становятся при определенных факторах. Это стафило- и стрептококки, диплококки, кишечная палочка, фузобактерии, клебсиеллы и многие другие. Они участвуют в создании равновесия и также играют определенную роль в здоровье женщины, если не достигают запредельных концентраций.
В силу каких-то обстоятельств количество «главных регуляторов количества микробов» палочек Дедерлейна снижается. В результате ниши на слизистой влагалища начинают занимать условно-патогенные.
Процесс их размножения становится настолько активным, что в итоге палочки Дедерлейна могут даже не обнаруживаться в обычном мазке. Продукты их жизнедеятельности, а также они сами и обусловливают появление специфических выделений. Характер их зависит от преобладающего состава микробов и может варьировать от сероватого до зеленого и гнойного желтого.
Также к этой группе можно отнести кандидозный кольпит, несмотря на то, что он вызывается дрожжевым грибком, по сути, это просто дисбиоз во влагалище.
Специфическое воспаление
Специфическое воспаление возникает, если во влагалище проникают облигатные патогены, т.е. те, в норме которых быть не должно. Например, это трихомонады, хламидии, гонококки и многие другие.
Попадая во влагалище, патогены, даже несмотря на большое количество палочек Дедерлейна и кислую среду, начинают активно размножаться и тем самым нарушают нормальную флору. Через некоторое время они уже значительно превалируют по численности среди остальных микроорганизмов. Чаще всего это сопровождается яркой клинической картиной, за исключением некоторых инфекций.
Кольпит после родов — распространенная проблема, о которой говорят многие женщины. Основные причины его возникновения связаны с изменениями в гормональном фоне, ослаблением иммунной системы и нарушением микрофлоры влагалища. После родов организм нуждается в восстановлении, и любые инфекции могут легко проявиться. Женщины отмечают, что симптомы кольпита, такие как зуд, жжение и выделения, могут значительно ухудшить качество жизни.
Для избавления от кольпита важно обратиться к врачу, который назначит необходимые анализы и лечение. Обычно это включает в себя антибактериальные или противогрибковые препараты, а также средства для восстановления микрофлоры. Некоторые женщины также рекомендуют использовать пробиотики и соблюдать гигиену, чтобы предотвратить повторное возникновение проблемы. Важно помнить, что своевременное обращение за медицинской помощью и соблюдение рекомендаций врача помогут быстро справиться с кольпитом и восстановить здоровье.

Провоцирующие кольпит факторы
Даже если роды протекали идеально, и женщина чувствует себя хорошо, организм находится в напряжении и иммунодефиците. Это физиологическое состояние, которое присутствует еще во время вынашивания. Именно поэтому беременные входят в группу риска по развитию всех инфекционных заболеваний, в том числа гриппа, герпеса, половых инфекций и т.п. Также развитие кольпита провоцируют следующие моменты:
- Большая кровопотеря в родах, которая будет усугублять состояние иммунодефицита. Тем более если проводилось переливание крови.
- Выполнение дополнительных манипуляций или даже кесарева сечения.
- Травмы и разрывы влагалища. Все разрывы ушиваются стерильными хирургическим материалом, но постепенно на нитках адсорбируется кровь, и начинают размножаться микробы еще до того, как лигатуры сами рассосутся или их снимут.
- Если накануне родов у женщины было воспаление во влагалище, особенно если она не успела пройти весь курс лечения до родов.
- Недостаточно тщательная послеродовая гигиена.
- Изменение работы эндокринных органов после родов. Особенно это касается женщин, еще до беременности имеющих проблемы со щитовидной железой, гипофизом и т.п.
Несвоевременная коррекция уровня гормонов может провоцировать снижение защитных сил (падает иммунитет, уменьшается количество слизи во влагалище и т.п.) и кольпит. Особое внимание в этом плане следует уделять женщинам после ЭКО.
Признаки и симптомы кольпита у мамы
Как только кровянистые выделения у женщины ослабевают, если воспаление во влагалище есть, она может заметить его признаки. К основным можно отнести следующие:
- Выделения по количеству больше обычного, иногда для гигиены не хватает даже ежедневных прокладок. Сюда не входят ситуации, когда еще не закончились лохии.
- Выделения имеют нездоровый цвет, например, они могут быть зеленоватого, желтоватого оттенка, быть пенистыми или белыми, творожистыми и т.д.
- Бели чаще всего имеют специфический запах. Это может напоминать чем-то рыбный оттенок, чрезмерно кислый, зловонный и неприятный и т.п.
- Часто при этом появляется зуд и жжение в области половых органов за счет раздражения кожи и слизистой патологическими выделениями.
- Может возникать отек в области раздражения. Чаще всего он локализуется на малых или больших половых губах, реже – на промежности.
- Температура тела остается нормальной, но если воспаление из влагалища проникает в полость матки и придатки, может подниматься до субфебрильной или даже больше. Все зависит от патогенной флоры и иммунитета женщины.
- Боли внизу живота сопровождают воспаление во влагалище, если вовлекается полость матки, придатки, возникает бартолинит и т.п.

Виды кольпита после родов
Кольпит после родов ничем не отличается от обычного воспаления, которое может развиваться у женщины. Из неспецифических чаще всего возникают следующие:
- Бактериальный вагиноз. Иногда данное состояние относится в категорию воспаления, но это скорее нарушение флоры влагалища. Дело в том, что очень часто бактериальный вагиноз развивается на фоне какой-то инфекции, именно поэтому его и классифицируют как кольпит. В этом состоянии у женщины резко снижается количество палочек Дедерлейна, что приводит к местному снижению иммунитета и высокому риску воспаления. Основной маркер состояния – ключевые клетки в мазке и обнаружение гарднерелл.
- Кандидозный кольпит развивается в ситуации, когда ввиду уменьшения молочнокислых бактерий дрожжевые грибы начинают активно размножаться. Особенно актуально это после родов, когда иммунитет женщины ослаблен, ей чаще приходится применять антибиотики (по поводу мастита, после кесарева сечения и т.п.).
- Вагинит возникает при активации условно-патогенной флоры, которую можно выявить специальными исследованиями. В обычных мазках будут только признаки воспаления. Чаще всего причина – кишечная палочка, стрепто- и стафилококки.
Специфические кольпиты возникают после незащищенных половых контактов. Но возможно и бытовое заражение, например, в бане или сауне, если использовать общие средства гигиены и т.д.
Основные специфические кольпиты следующие:
- Трихомонадный, при этом появляются пенистые зеленовато-гнойные выделения, достаточно обильные. Для диагностики хватит обычного мазка на флору из заднего свода влагалища.
- Гонорейный, встречается реже, но имеет яркую клиническую картину: обильные гнойные выделения, отек и покраснение наружных половых органов. Желательно проходить лечение в стационаре.
- Хламидийный. Характеризуется незначительными белыми сливкообразными выделениями. Также может протекать скрыто. Это воспаление чаще других дает такие осложнения, как бесплодие, хронический аднексит и т.п.
- Уреа- и микоплазменный в большинстве случаев протекают с минимальными симптомами.
Осложнения, которые принесет кольпит в жизнь
Кольпит неприятен не только своими симптомами, но и теми осложнениями, которые развиваются при игнорировании проблемы. Чаще всего приходится сталкиваться со следующим:
- Распространение воспаления на полость матки (возникает эндометрит), придатки. После родов скорость прогрессирования заболевания значительна выше, а его конечные результаты (вплоть до абсцессов и пельвиоперитонита) развиваются быстрее.
- Плохое заживление травм влагалища и промежности. Иногда на фоне воспаления лигатуры могут полностью расходиться. После этого резко увеличивается вероятность развития несостоятельности мышц тазового дна, выпадения стенок влагалища и всех вытекающих отсюда последствий. Конечно, возникает это не сразу, а со временем, через 5 10 лет после осложненных родов.
- Тесный контакт между мамой и малышом может привести к попаданию инфекции к крохе. Чаще всего затрагиваются глаза с возникновением конъюнктивита, а также появляются вульвовагиниты у новорожденных девочек.
Диагностика кольпита после родов
Диагностика воспаления во влагалище включает в себя несколько этапов. К ним относятся:
- Осмотр слизистой влагалища и шейки матки в зеркалах. По характеру выделений можно уже предположить патологию, также это необходимо для определения дальнейшего диагностического пути.
- Мазок на флору из заднего свода влагалища и шейки матки. Так можно выявить бактериальный вагиноз, кандидозный кольпит, трихомониаз.
- ПЦР на инфекции, минимальный перечень – хламидии, мико- и уреаплазмы.
- Посев флоры влагалища на бактериальный состав и чувствительность к антибактериальным препаратам. Это исследование определяет количество возбудителей, так как условно-патогенная флора может присутствовать и в норме. Также это помогает подобрать наиболее эффективные препараты для лечения.
- Реже используется ИФА на инфекции, передающиеся половым путем. Этот метод не дает однозначных результатов, поэтому иногда сложно сказать, болеет сейчас женщина или перенесла такое воспаление ранее.
Лечение кольпита при лактации
Схема лечение воспаления во влагалище зависит от многих факторов. В частности, важно следующее:
- насколько острый процесс;
- проходила ли женщина лечение ранее по поводу такой же проблемы;
- есть ли постоянный половой партнер;
- поддерживает ли она лактацию;
- какое обследование она прошла (полное или просто мазок на флору из влагалища) и некоторые другие аспекты.
После уточнения всех нюансов гинеколог составляет схему терапии. Попытки самостоятельного лечения могут только усугубить воспаление и привести к переходу процесса в хроническую форму.
Для каждого вида кольпита своя принципиально отличная схема. Так, при кандидозном воспаление основное – противогрибковые препараты, при трихомонадном – чаще всего метронидазол, при уреаплазмах – другие антибиотики и т.п.
Основные группы препаратов следующие:
- Антибиотики: макролиды, пенициллинового, тетрациклинового ряда и другие. Идеально выбирать препарат с учетом чувствительности флоры. Это основное лечение при таких инфекциях, как хламидии, микоплазмы и т.п.
- Противомикробные препараты, чаще всего используется метронидазол (при баквагинозе, трихомониазе и т.п.). Очень часто данное лекарство входит в состав комбинированных свечей.
- Противогрибковые препараты назначаются при молочнице, а также как профилактика ее развития при использовании антибиотиков системно.
- При необходимости добавляется противовирусная терапия, если есть признаки такого поражения.
- Иммуномодуляторы, наиболее популярны средства из группы интерферона (руферон, генферон и подобные).
- Разнообразные свечи. Это могут быть как монопрепараты, так и комбинированные. Последним чаще отдается предпочтение, особенно при не совсем тщательном обследовании или при подозрении на микст-инфекцию. Комбинированные препараты (Тержинан, Полижинакс и другие) могут содержать гормоны, противогрибковый компонент, антибиотик. Поэтому они позволяют наиболее быстро устранить симптомы, такие как зуд, жжение и т.п.
- Препараты для восстановления микрофлоры после санации. Как правило, это лекарства на основе молочнокислых бактерий (Бифидумбактерин, Лактожиналь и другие).
Обязательным является лечение партнера, иначе женщина опять заболеет после очередного полового контакта.
Надо ли прерывать грудное вскармливание
Вопрос о прерывании грудного вскармливания решается в индивидуальном порядке. В большинстве случаев можно подобрать схемы с минимальными рисками для малыша. Но некоторые инфекции (гонорея, трихомониаз), а также устойчивые формы патогенов часто требуют назначения токсичных лекарств. В этих ситуациях от грудного вскармливания придется отказаться на время лечения, но это в среднем 7 14 дней, что не так критично.
Рекомендуем прочитать статью о выделениях после родов с неприятным запахом. Из нее вы узнаете о причинах выделений и признаках воспаления, необходимости обращения к врачу и лечении.
А здесь подробнее о заболеваниях после родов.
Кольпит после родов представляет реальную угрозу для здоровья женщины и малыша. Поэтому при подозрении на него лучше без замедления обратиться за медицинской помощью. Только специалисты могут установить истинную причину жалоб и при необходимости назначить наиболее безопасное и действенное лечение.
Вопрос-ответ
Можно ли вылечить кольпит навсегда?
Кольпит (вагинит) представляет собой воспалительное заболевание, локализующееся во влагалище и проявляющееся зудом, жжением, специфическими выделениями. При правильном лечении следует полное выздоровление. При отсутствии терапии болезнь принимает хроническую форму, и возникает угроза развития осложнения.
Можно ли заразить кольпитом мужчину?
Специфический кольпит вызывают инфекции, передающиеся половым путём, гонококки. Можно заразиться от полового партнёра. Для назначения лечения потребуется провести тест на чувствительность микробов к антибиотикам.
Советы
СОВЕТ №1
Обратитесь к врачу. Если вы заметили симптомы кольпита, такие как зуд, жжение или необычные выделения, не откладывайте визит к гинекологу. Специалист поможет определить причину и назначит соответствующее лечение.
СОВЕТ №2
Соблюдайте гигиену. Регулярное соблюдение интимной гигиены поможет предотвратить развитие кольпита. Используйте мягкие, неагрессивные средства для мытья и избегайте использования ароматизированных продуктов.
СОВЕТ №3
Следите за своим питанием. Здоровая диета, богатая витаминами и минералами, поддерживает иммунную систему и может помочь организму справиться с инфекциями. Увлажнение и употребление пробиотиков также могут быть полезными.
СОВЕТ №4
Избегайте стресса. Стресс может негативно сказаться на вашем здоровье, в том числе на состоянии влагалищной флоры. Практикуйте методы релаксации, такие как йога или медитация, чтобы снизить уровень стресса.